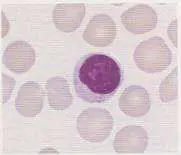
圖片
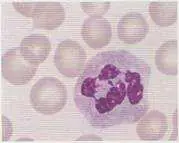
圖片

106年:(醫檢)血液(2)
下列二圖中的有核細胞的名稱分別為何?① ②
A①neutrophil ②lymphocyte
B①monocyte ②basophil
C①lymphocyte ②neutrophil
D①normoblast ②neutrophil
詳細解析
本題觀念:
本題考核周邊血液抹片(peripheral blood smear)中白血球(leukocytes)的型態學辨識,重點在於區分**淋巴球(lymphocyte)與嗜中性球(neutrophil)**這兩種最常見的白血球,透過細胞的核形、染色質型態與胞質特徵進行鑑別。
影像分析:
圖① — 有核細胞形態:
圖①顯示一個有核細胞(nucleated cell)位於多個紅血球(erythrocytes)之間,具備以下形態特徵:
- 細胞大小:約 6–9 μm,相對於周圍紅血球僅略大
- 細胞核:大而圓形,佔據細胞大部分體積(高核質比,high N/C ratio),染色質濃縮(dense chromatin)、深紫色,均一緻密,無明顯核仁
- 胞質:極少量,呈薄環狀淡藍色包圍細胞核,幾乎無顆粒
- 判定:符合**小淋巴球(small lymphocyte)**的典型型態
圖② — 有核細胞形態:
圖②顯示一個有核細胞,形態特徵如下:
- 細胞大小:約 12–14 μm,明顯大於淋巴球
- 細胞核:呈多葉型(multilobed/segmented),典型可見 3–5 個葉(lobes)以細絲(nuclear filaments)相連,染色質深紫色,葉間有明顯的縮窄
- **
...(解析預覽)...

升級 VIP 解鎖圖文解析